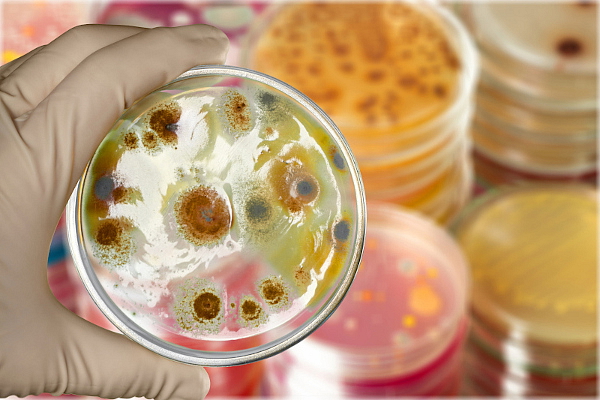
Fiberlogy CPE ANTIBAC Natural 1,75mm 500g

Fiberlogy CPE ANTIBAC Natural 1,75mm 500g
Podrobný popis
Dodatočné parametre
| Kategória: | CPE |
|---|---|
| EAN: | 5902560996715 |
| Farba: | prírodná |
| Hmotnosť: | 500 g |
| Materiál: | CPE |
| Priemer struny: | 1,75 mm |
| Výrobca: | Fiberlogy |
Buďte prvý, kto napíše príspevok k tejto položke.
Len registrovaní používatelia môžu pridávať hodnotenie. Prosím prihláste sa alebo sa zaregistrujte.
Buďte prvý, kto napíše príspevok k tejto položke.
Pridať komentár